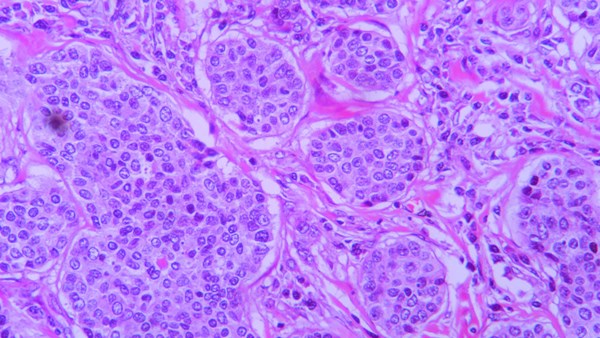

Back
Salivary Gland Cancers
These are a rare group of cancers. They represent less than 5% of all head and neck malignancies and can also present in other areas of the body, including the windpipe, breast, skin and the vulva. Surgery, where possible, followed by radiotherapy is the most common treatment. Supporting research and clinical trials is vital to improve survival and reduce side effects in all patients.